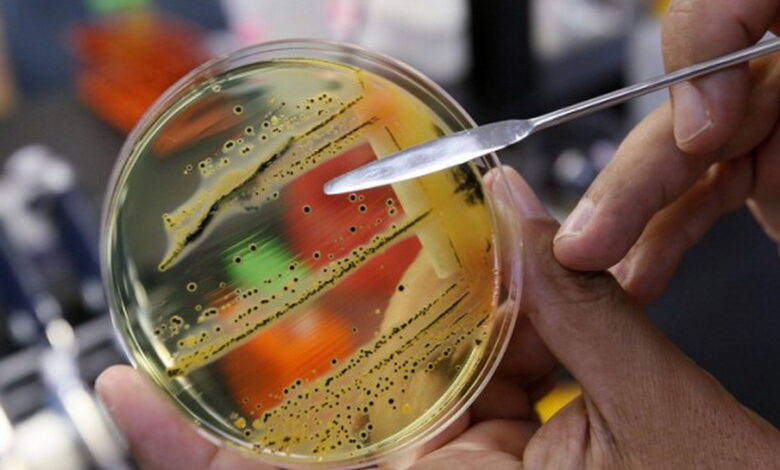
Сальмонела та ботулізм

Пищевые отравления в Николаеве: три угрозы жизни, пострадало 7 человек, у двоих - ботулизм
Инспектор главного управления прекратил оборот пищевых продуктов в количестве 20 кг
В течение первых пяти месяцев 2024 года Главное управление Госпродпотребслужбы в Николаевской области получило три сообщения о событиях и ситуациях, которые представляют угрозу жизни и здоровью населения, а также его санитарному и эпидемическому благополучию. Это сообщение касаются установленных фактов возможной связи между инфекционными болезнями, пищевыми отравлениями и деятельностью субъектов хозяйствования. Информация была получена от Государственного учреждения «Николаевский областной центр контроля и профилактики болезней Министерства здравоохранения Украины».
По информации Николаевского городского совета, согласно полученным сообщениям, пострадало 7 человек: пятеро заболели острым гастроэнтероколитом неустановленной этиологии, а двое — ботулизмом. Эти случаи были зарегистрированы на территории г. Николаева.
На основании указанных сообщений, государственные инспекторы управления безопасности пищевых продуктов и ветеринарной медицины Главного управления, вместе с инспекторами Николаевского городского управления, провели три мероприятия государственного контроля операторов рынка пищевых продуктов, деятельность которых связана со случаями инфекционных заболеваний.
По результатам проведенных мероприятий государственного контроля у одного оператора рынка выявлены нарушения законодательства о пищевых продуктах, в частности пункта 2 части первой статьи 48 Закона Украины № 771 «Об основных принципах и требования к безопасности и качеству пищевых продуктов». Оператору предоставлено предписание с установленными сроками для устранения нарушения.
Кроме того, во время мероприятий государственного контроля инспекторы Главного управления отобрали 12 образцов пищевых продуктов для исследования по показателям безопасности, в частности на выявление сальмонеллыи ботулизма. До завершения лабораторных исследований главный государственный инспектор Главного управления временно прекратил оборот пищевых продуктов в количестве 20,052 кг. По результатам лабораторных исследований, проведенных Николаевской региональной государственной лабораторией Держпродспоживслужбы, отобранные пищевые продукты соответствуют требованиям нормативных документов.
Также обращаются к населению с просьбой не покупать пищевые продукты у частных лиц в местах несанкционированной торговли, чтобы предотвратить возникновение пищевых отравлений.
Субъекты хозяйствования, которые осуществляют любую деятельность, связанную с пищевыми продуктами, должны зарегистрировать в Госпродпотребслужбе свои мощности по производству и/или обороту пищевых продуктов в соответствии с требованиями статей 23 и 25 Закона Украины «Об основных принципах и требования к безопасности и качеству пищевых продуктов».
Напомним, мы писали: